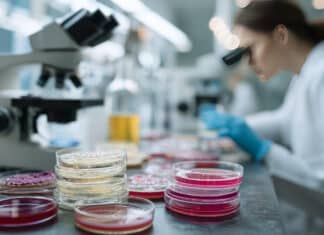

Tag: antibiotico-resistenza
Colliri contaminati, negli Usa 4 morti e 14 casi di perdita...
Negli Stati Uniti un raro batterio resistente ai farmaci collegato a colliri contaminati ha causato 4 morti, 14 casi di perdita della vista e il richiamo di diversi colliri da banco
Antibiotici, un solo ciclo può alterare il microbioma intestinale fino a...
Uno studio pubblicato su Nature Medicine rivela che anche un solo ciclo di antibiotici può alterare il microbioma intestinale per 4-8 anni. Gli effetti variano tra i farmaci e rafforzano l’allarme sull’uso non necessario di questi medicinali
Batteri resistenti agli antibiotici negli alimenti: l’allerta delle authority europee
Efsa e Ecdc pubblicano un rapporto congiunto sull'antibiotico-resistenza che "nei batteri di origine alimentare più comuni rimane elevata". Come dimostrano i risultati del nostro test su 12 hamburger: in 4 campioni ci sono microbi capaci di bucare lo scudo dei farmaci
Hamburger e antibiotico-resistenza: negli allevamenti troppi trattamenti preventivi
Enrico Moriconi, veterinario, sul nostro test: “Preoccupa la presenza nella carne di batteri resistenti alle cefalosporine, usate per curare le infezioni ospedaliere. Bisogna evitare in zootecnia la metafilassi: basse dosi a tutti i capi". I risultati pubblicati nel nuovo numero in edicola e in digitale
Antibiotico resistenza in 14 polli su 23: il test tedesco
Un test tedesco trova batteri resistenti agli antibiotici in 14 petti di pollo su 23, anche biologici. Non è un rischio immediato se ben cotto, ma segnala un problema globale: in Italia oltre 10mila morti l’anno
L’antibiotico-resistenza uccide più di influenza, Hiv e tubercolosi: oltre 35mila morti...
Ogni anno in Europa oltre 35mila persone muoiono per infezioni causate da batteri resistenti agli antibiotici. Numeri che superano i decessi per influenza, tubercolosi e Hiv messi insieme. Una minaccia sanitaria in crescita, come attestano i dati diffusi oggi dall'Ecdc
Scoperto farmaco contro il batterio killer resistente agli antibiotici
Pubblicato su Nature uno studio italiano della Toscana Life Sciences: la Klebsiella pneumoniae, batterio che può facilmente diffondersi negli ospedali, causare infezioni letali e per il quale gli attuali medicinali non funzionano, può essere curato con anticorpi monoclonali umani
Allarme dell’Oms: un’infezione su sei resistente agli antibiotici (inefficaci oltre il...
Aumentano le infezioni resistenti agli antibiotici: nel 2023 una su sei si è rivelata tale e oltre il 40% degli antibiotici ha perso efficacia...
Antibiotico-resistenza, il Regno Unito lancia l’allarme: “Rischiamo un’epidemia fuori controllo”
Il Regno Unito potrebbe trovarsi impreparato di fronte a una futura epidemia causata dai super-batteri: microrganismi resistenti agli antibiotici, che mettono a rischio la medicina moderna. A lanciare l’allarme è il Public Accounts Committee (PAC), un comitato parlamentare britannico
Azitromicina, l’Ema rivede gli usi: più cautela per evitare l’antibiotico-resistenza
L’Agenzia europea per i medicinali ha raccomandato modifiche sull’uso dell’antibiotico azitromicina, nel tentativo di contrastare lo sviluppo di resistenze antimicrobiche. Ecco le patologie per le quali non usarlo
Antibiotico-resistenza: Trump licenzia i veterinari e accontenta le lobby degli allevatori
140 licenziamenti dei dipendenti della Food and drug administration, in buona parte impiegati nella lotta all'antibiotico-resistenza e all'uso di farmaci negli allevamenti. Trump accontenta la lobby della carne a stelle e strisce
Antibiotici negli allevamenti: aumentano le vendite (e l’Italia non si risparmia)
È quanto testimoniano i dati del rapporto di sorveglianza dell'Ema. Dopo un periodo di diminuzione tornano a salire le vendite e i timori di antibiotico-resistenza. E in Italia, dove sono circa 10mila i morti ogni anno per queste cause, nonostante le dichiarazioni tranquillizzanti delle industrie l'uso rimane troppo alto